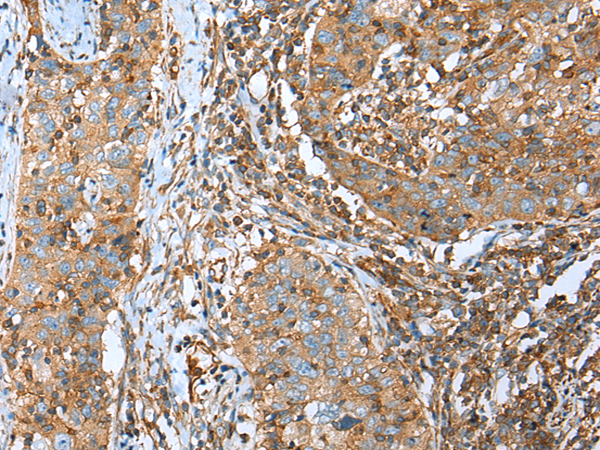

中文名稱: 兔抗TRPV6多克隆抗體
|
Background: |
This gene encodes a member of a family of multipass membrane proteins that functions as calcium channels. The encoded protein contains N-terminal ankyrin repeats, which are required for channel assembly and regulation. Translation initiation for this protein occurs at a non-AUG start codon that is decoded as methionine. This gene is situated next to a closely related gene for transient receptor potential cation channel subfamily V member 5 (TRPV5). This locus has experienced positive selection in non-African populations, resulting in several non-synonymous codon differences among individuals of different genetic backgrounds. |
|
Applications: |
ELISA, IHC |
|
Name of antibody: |
TRPV6 |
|
Immunogen: |
Synthetic peptide of human TRPV6 |
|
Full name: |
transient receptor potential cation channel, subfamily V, member 6 |
|
Synonyms: |
CAT1; CATL; ZFAB; ECAC2; ABP/ZF; LP6728; HSA277909 |
|
SwissProt: |
Q9H1D0 |
|
ELISA Recommended dilution: |
2000-5000 |
|
IHC positive control: |
Human esophagus cancer and human lung cancer |
|
IHC Recommend dilution: |
25-100 |

購(gòu)物車
幫助
021-54845833/15800441009
